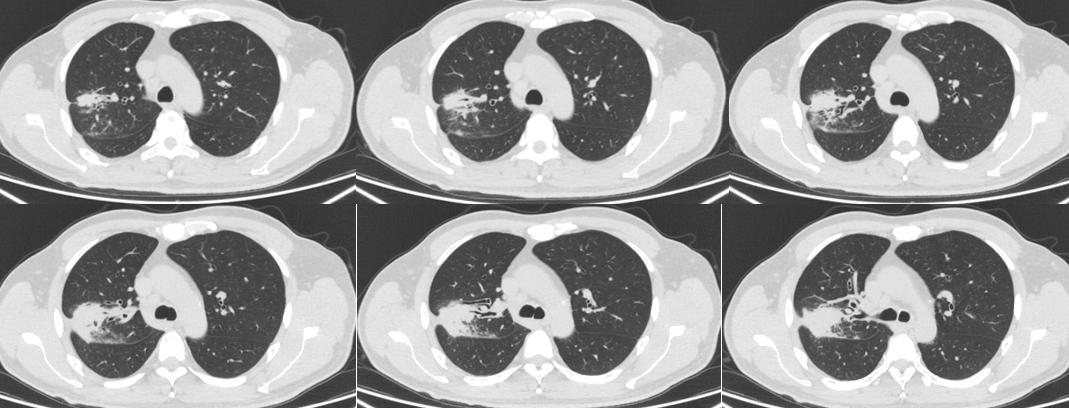
机化性肺炎用药多久复查ct,坠积性肺炎ct表现

病例一
病史:男性,50岁,主诉:咳嗽咳痰6月,发热半月
图像:

影像描述:右肺可见多发班片状、条片状、索条状密度增高灶,边界不清,边缘呈磨玻璃密度,病变内可见多发低密度区,增强扫描可见明显强化,低密度区未见明显强化,边界清,局部可见小空洞形成,周围可见多发纤维条索灶,与胸膜牵连,邻近胸膜及叶间裂局部增厚,病变区支气管管壁明显增厚。左肺下叶前内基底段胸膜下见一实性结节,截面大小约 0.6cm。段及段以上支气管通畅。右肺门及纵隔可见多发肿大淋巴结,大者大小约 2.2x1.2c。双侧胸腔未见明显液性密度灶。扫描野示肝左叶可见一类圆形异常强化灶,大小约 1.0cm;双侧肾上腺增粗。
影像诊断:右肺多发病变并右肺门、纵隔多发淋巴结肿大,首先考虑机化性肺炎,建议病理学检查除外瘤;
病理:未查见癌细胞,考虑机化性肺炎。
发言:有事,没怎么听进去早会。主要是边缘类似刀切征,周边还有毛玻璃,虽然有淋巴结肿大吧,还是没法除外计划性肺炎。
病例二
病史:女性,70岁。主诉:查体发现右肺上叶占位1周余。
图像:


影像描述:右肺上叶尖段见一不规则形混合磨玻璃密度灶,大小约 .7X4.2X4.5m,内可见多发小空腔中央部分较密实,周边可见斑片状密度增高影及毛刺,边界不清,邻近胸膜受牵拉,增强扫描实性成分可见强化:双肺另见多发点状结节灶,边界尚清,增强扫描未见明显强化。左肺上叶舌段见条索状密度增高灶,邻近胸膜受牵拉。段及以上支气管通畅。食管胸下段、胃责门及小弯侧胃壁略显增厚。纵隔内未见异常增大的淋巴结。双侧胸腔未见明显液性密度灶。
影像诊断:右肺上叶混合磨玻璃灶,鉴别于肺癌与机化性肺炎,建议病理学检查:双肺多发点状结节灶,建议随诊复查:
病理:腺癌。
发炎:混合磨玻璃,周边毛刺,胸膜牵拉。感觉还是先抗炎观察再说呗。倾向不好的东西。
老师总结:表示太忙了,没听见老师的点评